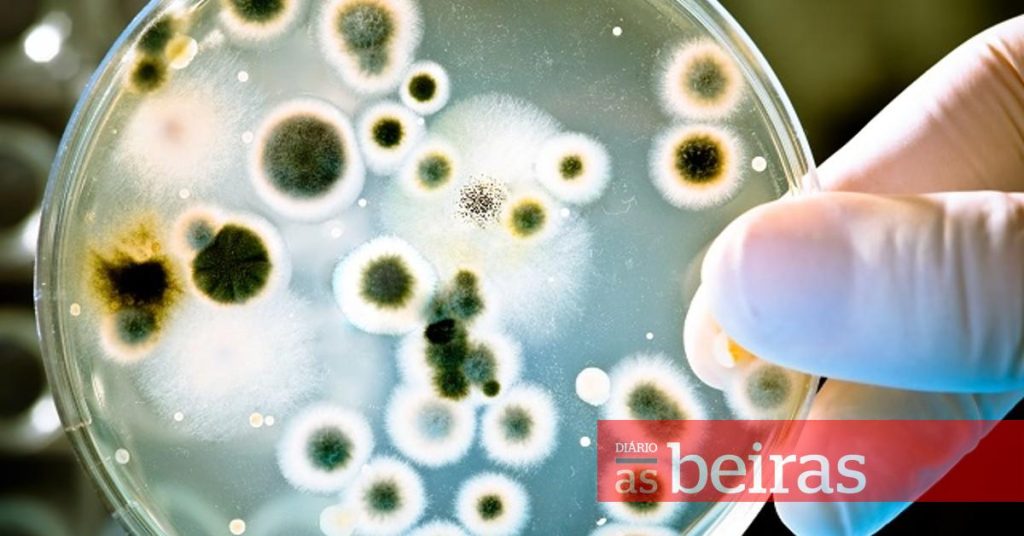

Cientistas de Coimbra usam bactérias para impressão a quatro dimensões
Sublinhando que o projeto “abre portas a um sem número de aplicações, desde a medicina até aos transportes e setor...

Projetos da UC e do IPC aprovados para programas do PRR
“Living for the Future Academy”, liderado pela Universidade de Coimbra, e “To Boost People and Territory”, do Politécnico de Coimbra,...

Universidade de Coimbra faz doação ao Museu Nacional do Brasil
A doação de uma coleção simbólica de conchas marítimas e terrestres é um passo no estreitar de relações entre o...

50 milhões instalam a referência europeia para estudar envelhecimento
Doze anos depois do primeiro passo deste processo, foi lançada ontem, no Polo III da Universidade de Coimbra, a obra...

Jogos Universidade de Coimbra querem bater recorde
O vice-reitor com o pelouro do Desporto declarou, ontem, oficialmente abertos os Jogos Universidade de Coimbra 2021/2022. Este ano o...

Fernando Ramos aposta na investigação na Faculdade de Farmácia
Antes, Fernando Ramos fizera questão de assumir a herança dos seus antecessores: fazer da faculdade uma das melhores, senão a...

Municípios com maior autonomia financeira comunicaram mais na pandemia
Um estudo sobre a comunicação dos municípios portugueses no Facebook durante a primeira vaga da pandemia de covid-19 concluiu que...

Santana Lopes anuncia polo da Universidade de Coimbra para breve
No discurso da tomada de posse, o novo presidente da Câmara da Figueira da Foz, que sucede ao socialista Carlos...

897 novos alunos entraram na 2ª fase em Coimbra
Na 2.ª fase, a UC colocou inicialmente 386 vagas, a que se juntaram mais 114 de inscrições não feitas durante...

PRR não pode justificar corte de verbas estatais, avisa reitor
Esta cerimónia pôde já dar testemunho de uma Sala dos Capelos com ocupação semelhante ao cenário pré-pandemia, facto enaltecido pelo...







